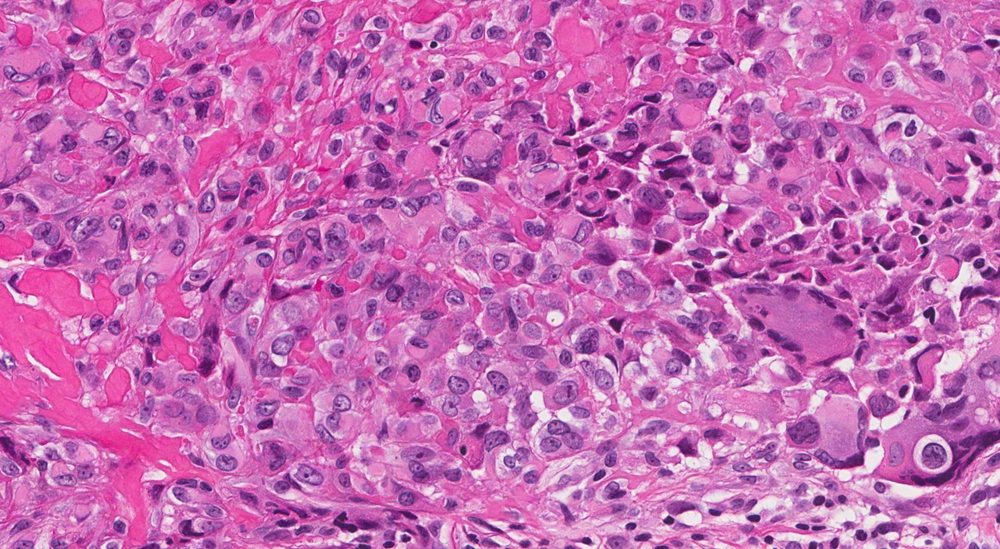
Phát hiện mắc ung thư cực hiếm sau hơn một năm chịu đựng đau bụng, sốt và các vấn đề tiết niệu dai dẳng: Tỷ lệ mắc chỉ 0,17 ca/1 triệu người - ảnh 2

Phát hiện mắc ung thư cực hiếm sau hơn một năm chịu đựng đau bụng, sốt và các vấn đề tiết niệu dai dẳng: Tỷ lệ mắc chỉ 0,17 ca/1 triệu người
(Thị trường tài chính) - Đây là một rối loạn mô bào rất hiếm, liên quan đến các bệnh lý ác tính về máu và u tế bào mầm, tỷ lệ mắc chỉ khoảng 0,17 ca trên 1 triệu người.
Một phụ nữ 48 tuổi đã được chẩn đoán mắc một dạng ung thư cực kỳ hiếm sau hơn một năm chịu đựng các triệu chứng đau bụng, sốt và vấn đề tiết niệu dai dẳng, dù đã trải qua nhiều ca phẫu thuật tại các cơ sở y tế.
Bệnh nhân N.T.L, quê ở Thái Bình, vừa được các bác sĩ tại Bệnh viện Bệnh Nhiệt đới Trung ương xác định mắc Sarcoma mô bào – một loại ung thư rất hiếm – sau một hành trình điều trị kéo dài với nhiều lần can thiệp phẫu thuật phức tạp liên quan đến hệ tiết niệu.
Trước khi nhập viện, chị L. đã điều trị tại nhiều nơi trong hơn một năm vì liên tục bị đau bụng, sốt và các dấu hiệu bất thường ở hệ tiết niệu. Ban đầu, chị được chẩn đoán ứ nước bể thận và nghi ngờ áp xe niệu quản. Sau đó, bệnh nhân trải qua hàng loạt phẫu thuật, bao gồm nội soi bóc áp xe, đặt ống niệu quản trái và phẫu thuật mở để tái tạo niệu quản do biến chứng thủng.

Bác sĩ thăm khám cho bệnh nhân. Ảnh: Người đưa tin
Sau ca mổ vào tháng 9/2024, tưởng rằng đã hồi phục, nhưng chị L. đột nhiên gặp tình trạng bí tiểu và sốt cao liên tục 40-41°C, không đáp ứng với kháng sinh. Chị được chuyển đến Bệnh viện Bệnh Nhiệt đới Trung ương trong tình trạng sốt kéo dài, đau bụng dưới ngày càng nặng, nhiễm trùng tiết niệu nghiêm trọng và nhiễm khuẩn huyết.
Kết quả siêu âm cho thấy niệu quản trái và đài bể thận giãn với đường kính khoảng 12mm, đồng thời phát hiện một ổ tổn thương hỗn hợp âm ở vùng tiểu khung trái, gần bàng quang, kích thước 49x36mm. Hình ảnh CT cho thấy một khối tăng tỷ trọng ở hố chậu trái, kích thước khoảng 51x60mm, xung quanh có dịch.
Qua thăm khám, các bác sĩ nhận thấy một khối u khá lớn và quyết định tiến hành hội chẩn liên chuyên khoa, sau đó thực hiện phẫu thuật mở cấp cứu để tìm nguyên nhân chính xác của bệnh.
Bác sĩ Trần Thượng Việt, Trưởng khoa Ngoại Tiết niệu và Nam học, chia sẻ: “Bệnh nhân đã trải qua nhiều lần phẫu thuật nhưng tình trạng vẫn tái phát. Qua thăm khám, chúng tôi phát hiện một khối u lớn gần tử cung trái, nghi ngờ ác tính, dù các xét nghiệm trước đó tại các cơ sở khác chỉ kết luận viêm hoặc áp xe. Vì vậy, chúng tôi quyết định mổ khẩn để loại bỏ toàn bộ khối u và làm giải phẫu bệnh, tránh trì hoãn thêm.”
Do đặc điểm hình thái và miễn dịch phức tạp, Sarcoma mô bào dễ bị nhầm với các loại u hoặc viêm khác như lymphoma, ung thư biểu mô kém biệt hóa, u hắc tố hoặc các sarcoma khác (Hình minh họa/Internet)
Ca mổ kéo dài 2 tiếng đã phát hiện hai khối u: một khối khoảng 3cm ở buồng trứng trái và một khối 4cm nằm sau tử cung, xâm lấn vào thành bàng quang. Cả hai khối u và một phần tử cung đã được cắt bỏ hoàn toàn. Sau phẫu thuật, sức khỏe bệnh nhân dần ổn định, vết mổ lành tốt và được chỉ định hóa trị tiếp theo.
Điều bất ngờ chỉ được hé lộ khi mẫu mô được gửi đi phân tích giải phẫu bệnh. Sau nhiều lần xét nghiệm, hội chẩn với các chuyên gia đầu ngành và thậm chí tham khảo ý kiến quốc tế, kết quả cuối cùng xác định bệnh nhân mắc Sarcoma mô bào (Histiocytic Sarcoma – HS), một dạng ung thư cực kỳ hiếm.
Bác sĩ Vũ Xuân Ngọc, Phụ trách khoa Giải phẫu bệnh học, cho biết Sarcoma mô bào là một rối loạn mô bào rất hiếm, liên quan đến các bệnh lý ác tính về máu và đôi khi kèm theo u tế bào mầm. Tỷ lệ mắc chỉ khoảng 0,17 ca trên 1 triệu người. Do đặc điểm hình thái và miễn dịch phức tạp, bệnh dễ bị nhầm với các loại u hoặc viêm khác như lymphoma, ung thư biểu mô kém biệt hóa, u hắc tố hoặc các sarcoma khác. Việc chẩn đoán đòi hỏi sự tỉ mỉ để loại trừ các khả năng khác.
Bệnh có biểu hiện đa dạng, có thể xuất hiện ở bất kỳ cơ quan nào và tiến triển nhanh với tính chất ác tính. Tuy nhiên, nếu được phát hiện sớm và điều trị kịp thời, bệnh nhân có thể có tiên lượng tốt hơn, ngay cả khi mắc phải loại ung thư hiếm gặp này.





